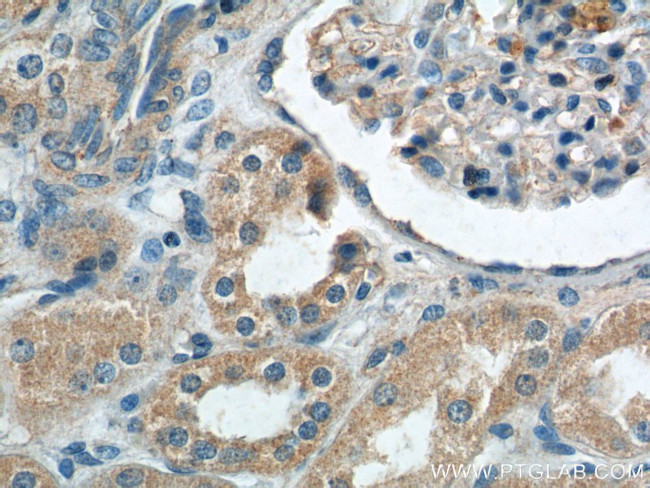
ECOP Antibody in Immunohistochemistry (Paraffin) (IHC (P))
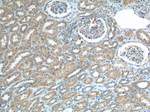
ECOP Antibody in Immunohistochemistry (Paraffin) (IHC (P))
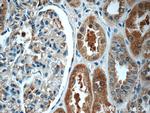
ECOP Antibody in Immunohistochemistry (Paraffin) (IHC (P))
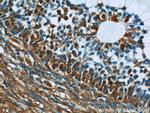
ECOP Antibody in Immunohistochemistry (Paraffin) (IHC (P))

Search
Proteintech
ECOP Polyclonal Antibody
{{$productOrderCtrl.translations['antibody.pdp.commerceCard.promotion.promotions']}}
{{$productOrderCtrl.translations['antibody.pdp.commerceCard.promotion.viewpromo']}}
{{$productOrderCtrl.translations['antibody.pdp.commerceCard.promotion.promocode']}}: {{promo.promoCode}} {{promo.promoTitle}} {{promo.promoDescription}}. {{$productOrderCtrl.translations['antibody.pdp.commerceCard.promotion.learnmore']}}
产品信息
12611-1-AP
种属反应
已发表种属
宿主/亚型
分类
类型
抗原
偶联物
形式
浓度
规格
纯化类型
保存液
内含物
保存条件
运输条件
产品详细信息
Immunogen sequence: KKHCWYFEG LYPTYYICRS YEDCCGSRCC VRALSIQRLW YFWFLLMMGV LFCCGAGFFI RRRMYPPPLI EEPAFNVSYT RQPPNPGPGA QQPGPPYYTD PGGPGMNPVG NSMAMAFQVP PNSPQGSVAC PPPPAYCNTP PPPYEQVVKA K (23-172 aa encoded by BC016650)
靶标信息
Increases the transcriptional activity of NFKB1 by facilitating its nuclear translocation, DNA-binding and associated apoptotic response, when overexpressed.
仅用于科研。不用于诊断过程。未经明确授权不得转售。
生物信息学
蛋白别名: DKFZP564K0822; ECop; EGFR-coamplified and overexpressed protein; Glioblastoma-amplified secreted protein; hypothetical protein DKFZp564K0822; Putative NF-kappa-B-activating protein 055N; unnamed protein product; Vesicular, overexpressed in cancer, prosurvival protein 1; VOPP1, WBP1/VOPP1 family member; WW domain binding protein VOPP1
基因别名: AW146242; ECOP; GASP; RGD1306494; VOPP1; WBP1L2
UniProt ID: (Human) Q96AW1, (Rat) B5DEK8, (Mouse) Q8R1C3
Entrez Gene ID: (Human) 81552, (Rat) 362374, (Mouse) 232023